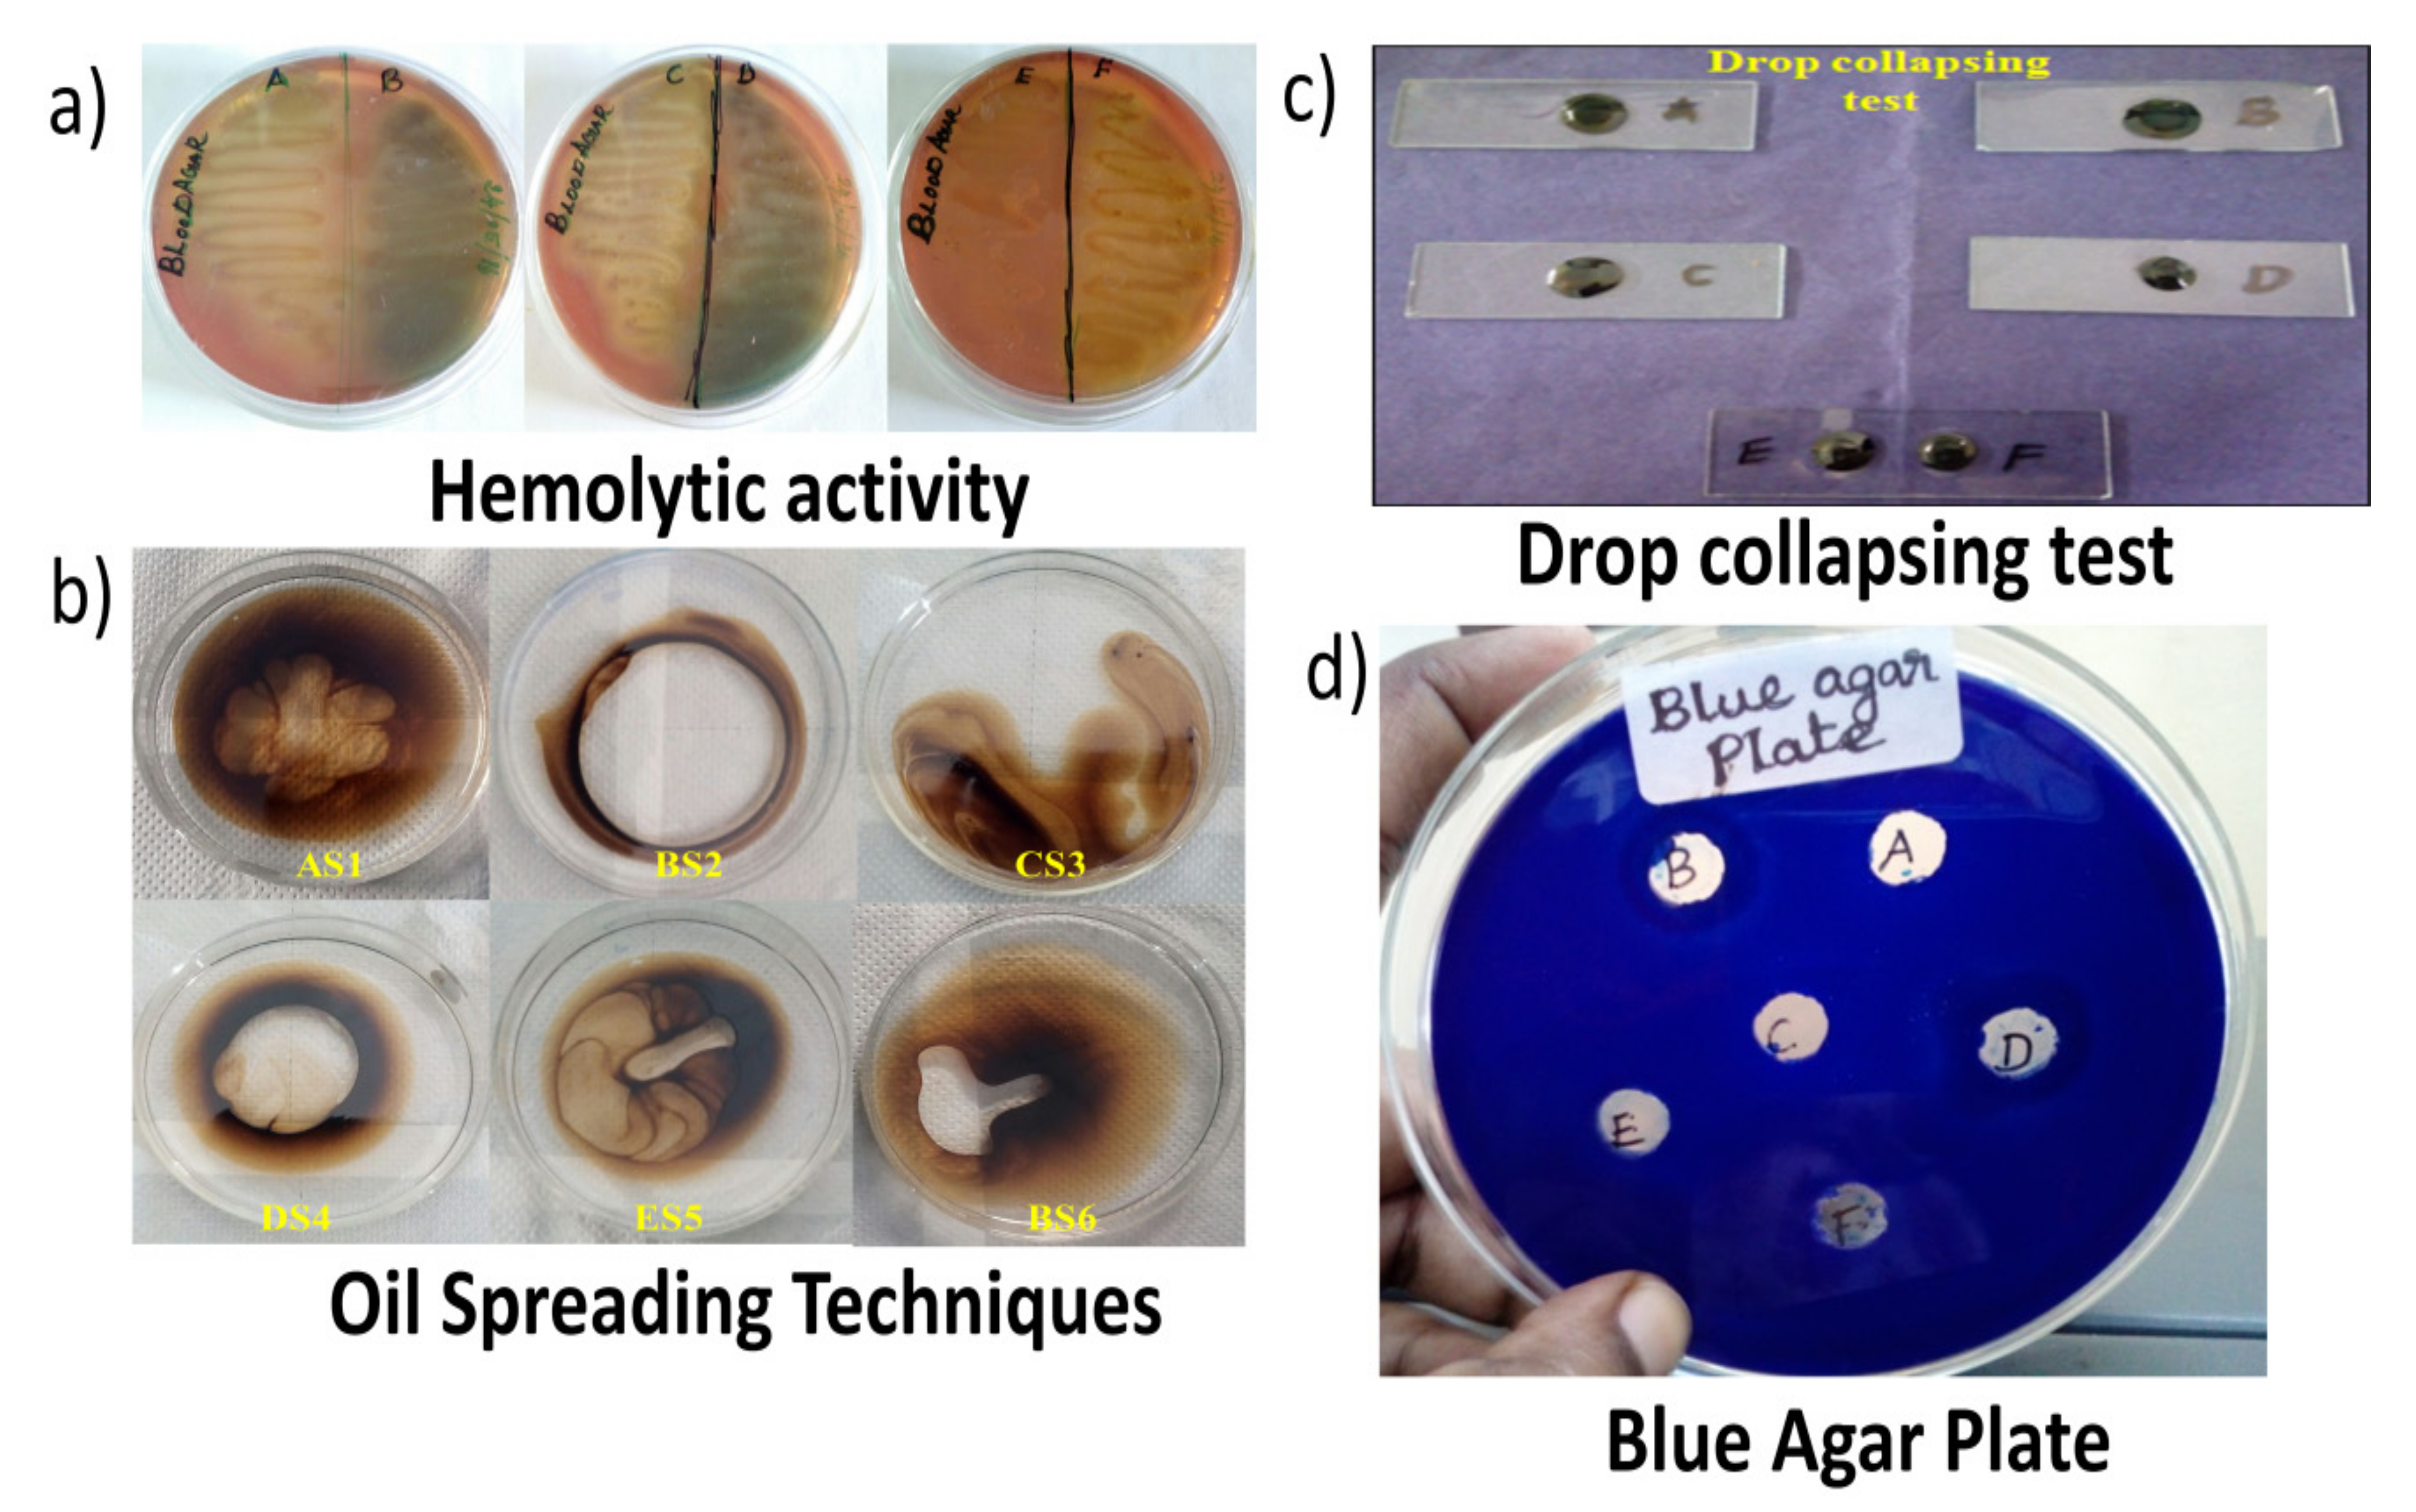
Sustainability 14 02142 g002 550

Production and Characterization of a Novel Biosurfactant Molecule from Bacillus safensis YKS2 and Assessment of Its Efficiencies in Wastewater Treatment by a Directed Metagenomic Approach
Abstract
:1. Introduction
2. Materials and Methods
2.1. Sample Collection and Isolation of Bacteria
2.2. Screening of Biosurfactant Producing Bacteria
2.2.1. Hemolytic Activity
2.2.2. Drop-Collapsing Test
2.2.3. Oil Spreading Assay
2.2.4. Blue Agar Plate (Bap) Method
2.3. Identification of Biosurfactant Production Strain
2.3.1. Morphology and Biochemical Characterization
2.3.2. Molecular Identification of the Biosurfactant Producing Bacteria
2.4. Optimization of Bacterial Culture Conditions by RSM
2.5. Extraction and Purification of Biosurfactant
2.6. Characterization of Biosurfactant
2.7. Biosurfactant-Mediated Wastewater Treatment and Microbial Community Analysis Using NGS Technique
2.8. Antibacterial Activity of Biosurfactant
2.9. Statistical Analysis
3. Result and Discussion
3.1. Isolation and Screening of Bacteria Producing Biosurfactant
3.2. Optimization of Biosurfactant Production
3.3. Characterization and Purification of Biosurfactant
3.4. Microbial Community Analysis in Biosurfactant-Treated Wastewater by Metagenomics Technique
3.4.1. Sequence Quality and Statistics
3.4.2. Microbial Classification
3.4.3. Rarefaction Curve and Krona Map
3.5. Antimicrobial Activity of the Biosurfactant
4. Conclusions
Author Contributions
Funding
Institutional Review Board Statement
Informed Consent Statement
Data Availability Statement
Acknowledgments
Conflicts of Interest
References
- Bezerra, K.G.O.; Rufino, R.D.; Luna, J.M.; Sarubbo, L.A. Saponins and microbial biosurfactants: Potential raw materials for the formulation of cosmetics. Biotechnol. Prog. 2018, 34, 1482–1493. [Google Scholar] [CrossRef] [PubMed]
- Hanano, A.; Shaban, M.; Almousally, I. Biochemical, molecular and transcriptional highlights of the biosynthesis of an effective biosurfactant produced by Bacillus safensis PHA3, a petroleum-dwelling bacteria. Front. Microbiol. 2017, 8, 77. [Google Scholar] [CrossRef] [PubMed] [Green Version]
- Santos, D.K.F.; Rufino, R.D.; Luna, J.M.; Santos, V.A.; Sarubbo, L.A. Biosurfactants: Multifunctional biomolecules of the 21st century. Inter. J. Mol. Sci. 2016, 17, 401. [Google Scholar] [CrossRef] [PubMed] [Green Version]
- Khopade, A.; Ren, B.; Liu, X.Y.; Mahadik, K.; Zhang, L.; Kokare, C. Production and characterization of biosurfactant from marine Streptomyces species B3. J. Colloid Interf. Sci. 2012, 367, 311–318. [Google Scholar] [CrossRef]
- Akbari, S.; Abdurahman, N.H.; Yunus, R.M.; Fayaz, F.; Alara, O.R. Biosurfactants—A new frontier for social and environmental safety: A mini review. Biotechnol. Res. Innov. 2018, 2, 81–90. [Google Scholar] [CrossRef]
- Silva, A.C.S.D.; Santos, P.N.D.; Andrade, R.F.S.; Campos Takaki, G.M. Biosurfactant production by fungi as a sustainable alternative. Arq. Instituto Biol. 2018, 85. [Google Scholar] [CrossRef] [Green Version]
- Sil, J.; Dandapat, P.; Das, S. Health care applications of different biosurfactants: Review. Int. J. Sci. Res. 2017, 6, 41–50. [Google Scholar]
- Khopade, A.; Biao, R.; Liu, X.; Mahadik, K.; Zhang, L.; Kokare, C. Production and stability studies of the biosurfactant isolated from marine Nocardiopsis sp. B4. Desalination 2012, 285, 198–204. [Google Scholar] [CrossRef]
- Xu, M.; Fu, X.; Gao, Y.; Duan, L.; Xu, C.; Sun, W.; Li, Y.; Meng, X.; Xiao, X. Characterization of a biosurfactant-producing bacteria isolated from Marine environment: Surface activity, chemical characterization and biodegradation. J. Environ. Chem. Eng. 2020, 8, 104277. [Google Scholar] [CrossRef]
- Usman, M.M.; Dadrasnia, A.; Lim, K.T.; Mahmud, A.F.; Ismail, S. Application of biosurfactants in environmental biotechnology; remediation of oil and heavy metal. AIMS Bioeng. 2016, 3, 289–304. [Google Scholar] [CrossRef]
- Cerrone, F.; Radivojevic, J.; Nikodinovic Runic, J.; Walsh, M.; Kenny, S.T.; Babu, R.; O’Connor, K.E. Novel sodium alkyl-1, 3-disulfates, anionic biosurfactants produced from microbial polyesters. Coll. Surf. B Biointerfaces 2019, 182, 110333. [Google Scholar] [CrossRef]
- Chaprao, M.J.; Rita De Cassia, F.; Rufino, R.D.; Luna, J.M.; Santos, V.A.; Sarubbo, L.A. Production of a biosurfactant from Bacillus methylotrophicus UCP1616 for use in the bioremediation of oil-contaminated environments. Ecotoxicology 2018, 27, 1310–1322. [Google Scholar] [CrossRef]
- Akyol, C.; Ince, O.; Bozan, M.; Ozbayram, E.G.; Ince, B. Biological pretreatment with Trametes versicolor to enhance methane production from lignocellulosic biomass: A metagenomic approach. Ind. Crops Prod. 2019, 140, 111659. [Google Scholar] [CrossRef]
- Walter, V.; Syldatk, C.; Hausmann, R. Screening concepts for the isolation of biosurfactant producing microorganisms. Adv. Exp. Med. Biol. 2010, 672, 1–13. [Google Scholar]
- Wattanaphon, H.T.; Kerdsin, A.; Thammacharoen, C.; Sangvanich, P.; Vangnai, A.S. A Biosurfactant from Burkholderiacenocepacia BSP3 and its enhancment of pesticide solubilization, Thailand. J. Appl. Microbiol. 2008, 105, 416–423. [Google Scholar] [CrossRef]
- Youssef, N.H.; Duncan, K.E.; Nagle, D.P.; Savage, K.N.; Knapp, R.M.; McInerney, M.J. Comparison of methods to detect biosurfactant production by diverse microorganisms. J. Microbiolog. Methods 2004, 56, 339–347. [Google Scholar] [CrossRef]
- Perfumo, A.; Banat, I.M.; Marchant, R. Going green and cold: Biosurfactants from low-temperature environments to biotechnology applications. Trends Biotechnol. 2018, 36, 277–289. [Google Scholar] [CrossRef] [Green Version]
- Maneerat, S.; Phetrong, K. Isolation of biosurfactant-producing marine bacteria and characteristics of selected biosurfactant. Songklanakarin J. Sci. Technol. 2007, 29, 781–791. [Google Scholar]
- Thaniyavarn, J.; Roongsawang, N.; Kameyama, T.; Haruki, M.; Imanaka, T.; Morikawa, M.; Kanaya, S. Production and characterization of biosurfactants from Bacillus licheniformis F2. Biosci. Biotechnol. Biochem. 2003, 67, 1239–1244. [Google Scholar] [CrossRef]
- Satpute, S.K.; Bhawsar, B.D.; Dhakephalkar, P.K.; Chopade, B.A. Assessment of different screening methods for selecting biosurfactant producing marine bacteria. Indian J. Geo-Mar. Sci. 2008, 37, 243–250. [Google Scholar]
- Cappuccino, J.G.; Sherman, N. Microbiology-a Laboratory Manual; Harlow: Essex, UK, 1999. [Google Scholar]
- Barakat, K.M.; Hassan, S.W.; Darwesh, O.M. Biosurfactant production by haloalkaliphilic Bacillus strains isolated from Red Sea, Egypt. Egypt J. Aquat. Res. 2017, 43, 205–211. [Google Scholar] [CrossRef]
- Kumar, S.; Stecher, G.; Tamura, K. MEGA7: Molecular evolutionary genetics analysis version 7.0 for bigger datasets. Mol. Biol. Evol. 2016, 33, 1870–1874. [Google Scholar] [CrossRef] [PubMed] [Green Version]
- Aktas, N.; Boyacı, I.H.; Mutlu, M.; Tanyolac, A. Optimization of lactose utilization in deproteinated whey by Kluyveromycesmarxianus using response surface methodology (RSM). Bioresour. Technol. 2006, 97, 2252–2259. [Google Scholar] [CrossRef]
- Najafi, A.R.; Rahimpour, M.R.; Jahanmiri, A.H.; Roostaazad, R.; Arabian, D.; Soleimani, M.; Jamshidnejad, Z. Interactive optimization of biosurfactant production by Paenibacillus alvei ARN63 isolated from an Iranian oil well. Colloids Surf. B Biointerfaces 2011, 82, 33–39. [Google Scholar] [CrossRef] [PubMed]
- Yadav, A.K.; Manna, S.; Pandiyan, K.; Singh, A.; Kumar, M.; Chakdar, H.; Kashyap, P.L.; Srivastava, A.K. Isolation and characterization of biosurfactant producing Bacillus sp. from diesel fuel-contaminated site. Microbiology 2016, 85, 56–62. [Google Scholar] [CrossRef]
- Wang, W.L.; Xu, S.Y.; Ren, Z.G.; Tao, L.; Jiang, J.W.; Zheng, S.S. Application of metagenomics in the human gut microbiome. World J. Gastroenterol. WJG 2015, 21, 803. [Google Scholar] [CrossRef]
- Tang, J.; Bu, Y.; Zhang, X.X.; Huang, K.; He, X.; Ye, L.; Shan, Z.; Ren, H. Metagenomic analysis of bacterial community composition and antibiotic resistance genes in a wastewater treatment plant and its receiving surface water. Ecotoxocol. Environ. Saf. 2016, 132, 260–269. [Google Scholar] [CrossRef]
- Klindworth, A.; Pruesse, E.; Schweer, T.; Peplies, J.; Quast, C.; Horn, M.; Glockner, F.O. Evaluation of general 16S ribosomal RNA gene PCR primers for classical and next-generation sequencing-based diversity studies. Nucleic Acids Res. 2013, 41, 1. [Google Scholar] [CrossRef]
- Das, P.; Mukherjee, S.; Sen, R. Antimicrobial potential of a lipopeptide biosurfactant derived from a marine Bacillus circulans. J. Appl. Microbiol. 2008, 104, 1675–1684. [Google Scholar] [CrossRef]
- Mizumoto, S.; Shoda, M. Medium optimization of antifungal lipopeptide, iturin A, production by Bacillus subtilis in solid-state fermentation by response surface methodology. Appl. Microbiol. Biotechnol. 2007, 76, 101–108. [Google Scholar] [CrossRef]
- Wei, Q.F.; Mather, R.R.; Fotheringham, A.F. Oil removal from used sorbents using a biosurfactant. Bioresour. Technol. 2005, 96, 331–334. [Google Scholar] [CrossRef]
- Santos, A.P.P.; Silva, M.D.S.; Costa, E.V.L.; Rufino, R.D.; Santos, V.A.; Ramos, C.S.; Sarubbo, L.A.; Porto, A.L.F. Production and characterization of a biosurfactant produced by Streptomyces sp. DPUA 1559 isolated from lichens of the Amazon region. Brazil. Braz. J. Med. Biol. Res. 2018, 51. [Google Scholar] [CrossRef]
- Moshtagh, B.; Hawboldt, K.; Zhang, B. Optimization of biosurfactant production by Bacillus subtilis N3-1P using the brewery waste as the carbon source. Environ. Technol. 2018, 40, 1–10. [Google Scholar] [CrossRef]
- Deepali, K.; Sneha, P.; Sucheta, P. Larvicidal activity of rhamnolipid biosurfactant produced by Stenotrophomonas maltophilia. Int. J. Sci. Eng. Res. 2014, 5, 60–63. [Google Scholar]
- Naughton, P.J.; Marchant, R.; Naughton, V.; Banat, I.M. Microbial Biosurfactants: Current trends and applications in Agricultural and Biomedical industries. J. Appl. Microbiol. 2019, 127, 12–28. [Google Scholar] [CrossRef] [Green Version]
- Mulligan, C.N.; Gibbs, B.F. Types, production and applications of biosurfactants. Proc. Indian Nat. Sci. Acad. 2004, 70, 31–55. [Google Scholar]
- Chebbi, A.; Hentati, D.; Zaghden, H.; Baccar, N.; Rezgui, F.; Chalbi, M.; Sayadi, S.; Chamkha, M. Polycyclic aromatic hydrocarbon degradation and biosurfactant production by a newly isolated Pseudomonas sp. strain from used motor oil-contaminated soil. Int. Biodeterior. Biodegrad. 2017, 122, 128–140. [Google Scholar] [CrossRef]
- Zou, C.; Wang, M.; Xing, Y.; Lan, G.; Ge, T.; Yan, X.; Gu, T. Characterization and optimization of biosurfactants produced by Acinetobacter baylyi ZJ2 isolated from crude oil-contaminated soil sample toward microbial enhanced oil recovery applications. Biochem. Eng. J. 2014, 90, 49–58. [Google Scholar] [CrossRef]
- El-Sheshtawy, H.S.; Aiad, I.; Osman, M.E.; Abo ELnasr, A.A.; Kobisy, A.S. Production of biosurfactants by Bacillus licheniformis and Candida albicans for application in microbial enhanced oil recovery. Egypt J. Pet. 2016, 25, 293–298. [Google Scholar] [CrossRef] [Green Version]
- Singh, P.; Tiwary, B.N. Isolation and characterization of glycolipid biosurfactant produced by a Pseudomonas otitidis strain isolated from Chirimiri coal mines, India. Bioresour. Bioprocess. 2016, 3, 42. [Google Scholar] [CrossRef] [Green Version]
- Ramani, K.; Jain, S.C.; Mandal, A.B.; Sekaran, G. Microbial induced lipoprotein biosurfactant from slaughterhouse lipid waste and its application to the removal of metal ions from aqueous solution. Colloids Surf. B Biointerfaces 2012, 97, 254–263. [Google Scholar] [CrossRef] [PubMed]
- Ohadi, M.; Dehghannoudeh, G.; Shakibaie, M.; Banat, I.M.; Pournamdari, M.; Forootanfar, H. Isolation, characterization, and optimization of biosurfactant production by an oil-degrading Acinetobacter junii B6 isolated from an Iranian oil excavation site. Biocatal. Agric. Biotechnol. 2017, 12, 1–9. [Google Scholar] [CrossRef]
- Jain, R.M.; Mody, K.; Joshi, N.; Mishra, A.; Jha, B. Production and structural characterization of biosurfactant produced by an alkaliphilic bacterium, Klebsiella sp.: Evaluation of different carbon sources. Colloids Surf. B Biointerfaces 2013, 108, 199–204. [Google Scholar] [CrossRef] [PubMed]
- Qiao, N.; Shao, Z. Isolation and characterization of a novel biosurfactant produced by hydrocarbon-degrading bacterium Alcanivoraxdieselolei B-5. J. Appl. Microbiol. 2010, 108, 1207–1216. [Google Scholar] [CrossRef]
- Martins, P.C.; Martins, V.G. Biosurfactant production from industrial wastes with potential remove of insoluble paint. Int. Biodeterior. Biodegrad. 2018, 127, 10–16. [Google Scholar] [CrossRef]
- Rodriguez-R, L.M.; Konstantinidis, K.T. Estimating coverage in metagenomic data sets and why it matters. ISME J. 2014, 8, 2349. [Google Scholar] [CrossRef] [Green Version]
- Zumsteg, A.; Luster, J.; Goransson, H.; Smittenberg, R.H.; Brunner, I.; Bernasconi, S.M.; Zeyer, J.; Frey, B. Bacterial, archaeal and fungal succession in the fore field of a receding glacier. Microb. Ecol. 2012, 63, 552–564. [Google Scholar] [CrossRef] [Green Version]
- Fierer, N.; Jackson, J.A.; Vilgalys, R.; Jackson, R.B. Assessment of soil microbial community structure by use of taxon-specific quantitative PCR assays. Appl. Environ. Microbiol. 2005, 71, 4117–4120. [Google Scholar] [CrossRef] [Green Version]
- Campanaro, S.; Treu, L.; Kougias, P.G.; De Francisci, D.; Valle, G.; Angelidaki, I. Metagenomic analysis and functional characterization of the biogas microbiome using high throughput shotgun sequencing and a novel binning strategy. Biotechnol. Biofuels 2016, 9, 26. [Google Scholar] [CrossRef] [Green Version]
- Stolze, Y.; Zakrzewski, M.; Maus, I.; Eikmeyer, F.; Jaenicke, S.; Rottmann, N.; Siebner, C.; Puhler, A.; Schlüter, A. Comparative metagenomics of biogas-producing microbial communities from production-scale biogas plants operating under wet or dry fermentation conditions. Biotechnol. Biofuels 2015, 8, 1–18. [Google Scholar] [CrossRef] [Green Version]
- Sriram, M.I.; Gayathiri, S.; Gnanaselvi, U.; Jenifer, P.S.; Raj, S.M.; Gurunathan, S. Novel lipopeptide biosurfactant produced by hydrocarbon degrading and heavy metal tolerant bacterium Escherichia fergusonii KLU01 as a potential tool for bioremediation. Bioresour. Technol. 2011, 102, 9291–9295. [Google Scholar] [CrossRef]
- Rodrigues, L.; Banat, I.M.; Teixeira, J.; Oliveira, R. Biosurfactants: Potential applications in medicine. J. Antimicrob. Chemothe. 2006, 57, 609–618. [Google Scholar] [CrossRef]
- Di Rienzo, V.; Fanelli, V.; Miazzi, M.M.; Savino, V.; Pasqualone, A.; Summo, C.; Giannini, P.; Sabetta, W.; Montemurro, C. A reliable analytical procedure to discover table grape DNA adulteration in industrial wines and musts. Acta Hortic. 2016, 1188, 365–370. [Google Scholar] [CrossRef]
- Mani, P.; Dineshkumar, G.; Jayaseelan, T.; Deepalakshmi, K.; Ganesh Kumar, C.; Senthil Balan, S. Antimicrobial activities of a promising glycolipid biosurfactant from a novel marine Staphylococcus saprophyticus SBPS 15. 3 Biotech 2016, 6, 1–9. [Google Scholar] [CrossRef] [Green Version]

| Source | Sum of Squares | df | Mean Square | F Value | p-Value Prob > F | |
|---|---|---|---|---|---|---|
| Model | 137.7693 | 14 | 9.840662 | 7.423361 | 0.0001 | significant |
| A-Glycerol | 0.058102 | 1 | 0.058102 | 0.04383 | 0.8372 | |
| B-Plam Jaggery | 4.586797 | 1 | 4.586797 | 3.460077 | 0.0840 | |
| C-Temperature | 2.608669 | 1 | 2.608669 | 1.967864 | 0.1825 | |
| D-pH | 0.2136 | 1 | 0.2136 | 0.16113 | 0.6942 | |
| AB | 0.1369 | 1 | 0.1369 | 0.103271 | 0.7527 | |
| AC | 0.200256 | 1 | 0.200256 | 0.151064 | 0.7034 | |
| AD | 0.64 | 1 | 0.64 | 0.482788 | 0.4985 | |
| BC | 0.36 | 1 | 0.36 | 0.271568 | 0.6104 | |
| BD | 9.06311 | 1 | 9.06311 | 6.83681 | 0.0204 | |
| CD | 0.01 | 1 | 0.01 | 0.007544 | 0.9320 | |
| A2 | 62.98868 | 1 | 62.98868 | 47.51587 | <0.0001 | |
| B2 | 50.33624 | 1 | 50.33624 | 37.97144 | <0.0001 | |
| C2 | 46.97904 | 1 | 46.97904 | 35.43891 | <0.0001 | |
| D2 | 22.45774 | 1 | 22.45774 | 16.94113 | 0.0010 | |
| Residual | 18.55888 | 14 | 1.325634 | 0.90369 | 0.1363 | |
| Lack of Fit | 18.55888 | 10 | 1.855888 | 0.9523 | 0.1769 | Not significant |
| Pure Error | 0 | 4 | 0 | |||
| Cor Total | 156.3282 | 28 |
| Vibrational Assignment | Observed Wave Number (cm−1) | Functional Group | Visible Intensity |
|---|---|---|---|
| O–Hstretch | 3296.17 | alkanes | mmall medium peak |
| C–H stretch | 3070.89 | amide | small medium peak |
| O–Hstretch | 2982.99 | carboxylic acids | medium peak |
| –N≡C stretch | 2137.59 | nitrogen | small medium peak |
| C=O stretch | 1729.22 | carboxylic acids | very sharp peak |
| Secondary amide C=O stretch | 1653.83 | amides | sharp peak |
| C–O stretch | 1287.24 | Esters | sharp peak |
| C–O stretch | 1074.55 | alcohol and phenols | very sharp peak |
| N–H stretch | 745.83 | amides | sharp peak |
| N–H stretch | 650.71 | amides | wide peak |
| S. No. | Retention Time | Molecular Formula | Molecular Weight | Compound Name | Structure |
|---|---|---|---|---|---|
| 1. | 12.313 | C14H25F3O2 | 282 | 3-Trifluoroacetoxydodecane | ![]() |
| 2. | 22.949 | C10H14O2 | 166 | Phenol, 3-Methoxy-2,4,6-Trime | ![]() |
| 3. | 23.517 | C17H36 | 240 | Heptadecane | ![]() |
| 4. | 24.146 | C13H13N3O | 227 | Hydrazinecarboxamide, N,N- | ![]() |
| 5. | 25.935 | C14H28 | 196 | 1-Dodecene, 2-Ethyl- | ![]() |
| 6. | 26.642 | C14H28O2 | 228 | Tetradecanoic Acid | ![]() |
| 7. | 30.077 | C7H11Cl | 130 | 1-(3-Chloropropyl)-2-Methyle | ![]() |
| 8. | 30.331 | C9H15Cl | 158 | (4Z)-5-Chloro-3,4-dimethyl-2,4-heptad | ![]() |
| 9. | 36.464 | C14H16N2O2 | 244 | Pyrrolo[1,2-a]pyrazine-1,4-dione, hexah | ![]() |
| Parameter | Control | Treated |
|---|---|---|
| pH | 8.9 | 7.1 |
| Electrical Conductivity (mMho/cm) | 940.00 | 241.66 |
| Turbidity (mg/L) | 22.35 | 16.39 |
| Total Suspended Solids (mg/L) | 968.33 | 289.16 |
| Total dissolved solids (mg/L) | 657.35 | 159.38 |
| Dissolved Oxygen (mg/L) | 243.05 | 197.39 |
| Chemical Oxygen Demand (mg/L) | 856.15 | 223.18 |
| Biological Oxygen Demand (mg/L) | 317.46 | 148.26 |
| S. No. | Control | Treated | ||
|---|---|---|---|---|
| Analysis Statistics | Total Number of Species | Analysis Statistics | Total Number of Species | |
| 1 | Upload: bp count | 41,951,574 bp | Upload: bp count | 25,454,968 bp |
| 2 | Upload: Sequences count | 139,374 | Upload: Sequences count | 84,568 |
| 3 | Upload: Mean sequences | 301 ± 0 bp | Upload: Mean sequences | 301 ± 0 bp |
| 4 | Upload: Mean GC percent | 55 ± 3% | Upload: Mean GC percent | 56 ± 2% |
| 5 | Artificial Duplicate Reads: Sequence count | 126,445 | Artificial Duplicate Reads: Sequence count | 78,076 |
| 6 | Post QC: bp count | 3,809,704 bp | Post QC: bp count | 1,943,367 bp |
| 7 | Post QC: Sequences count | 12.818 | Post QC: Sequences count | 6.483 |
| 8 | Post QC: Mean sequences | 297 ± 11 bp | Post QC: Mean sequences | 300 ± 14 bp |
| 9 | Post QC: Mean GC percent | 55 ± 3% | Post QC: Mean GC percent | 55 ± 3% |
| 10 | Processed: Predicted Protein Features | 156 | Processed: Predicted Protein Features | 62 |
| 11 | Processed: Predicted rRNA Features | 49.550 | Processed: Predicted rRNA Features | 22.905 |
| 12 | Alignment:Identifiedprotein Features | 22 | Alignment:Identifiedprotein Features | 6 |
| 13 | Alignment: Identified rRNA Feature | 44.900 | Alignment: Identified rRNA Feature | 21.905 |
| 14 | Annotation: Identified functional Categories | Undefined | Annotation: Identified functional Categories | Undefined |
| Strain Name | Standard Antibiotic (Ciprofloxacin) | Concentrations in µg/mL | ||||
|---|---|---|---|---|---|---|
| 20 | 40 | 60 | 80 | 100 | ||
| E. coli | 18.3 ± 0.4 | 2.6 ± 3.7 | 13.6 ± 0.4 | 13.7 ± 0.4 | 16.3 ± 0.5 | 19 ± 0.8 |
| S. aureus | 19 ± 0.8 | 5.3 ± 3.9 | 10 ± 0.8 | 13.3 ± 0.8 | 16.2 ± 0.8 | 20 ± 0.8 |
| K. pneumonia | 20.6 ± 0.4 | 10 ± 0.8 | 12.3 ± 0.4 | 13.6 ± 0.4 | 17 ± 0.8 | 21.6 ± 0.5 |
Publisher’s Note: MDPI stays neutral with regard to jurisdictional claims in published maps and institutional affiliations. |
© 2022 by the authors. Licensee MDPI, Basel, Switzerland. This article is an open access article distributed under the terms and conditions of the Creative Commons Attribution (CC BY) license (https://creativecommons.org/licenses/by/4.0/).
Share and Cite
Kalaimurugan, D.; Balamuralikrishnan, B.; Govindarajan, R.K.; Al-Dhabi, N.A.; Valan Arasu, M.; Vadivalagan, C.; Venkatesan, S.; Kamyab, H.; Chelliapan, S.; Khanongnuch, C. Production and Characterization of a Novel Biosurfactant Molecule from Bacillus safensis YKS2 and Assessment of Its Efficiencies in Wastewater Treatment by a Directed Metagenomic Approach. Sustainability 2022, 14, 2142. https://doi.org/10.3390/su14042142
Kalaimurugan D, Balamuralikrishnan B, Govindarajan RK, Al-Dhabi NA, Valan Arasu M, Vadivalagan C, Venkatesan S, Kamyab H, Chelliapan S, Khanongnuch C. Production and Characterization of a Novel Biosurfactant Molecule from Bacillus safensis YKS2 and Assessment of Its Efficiencies in Wastewater Treatment by a Directed Metagenomic Approach. Sustainability. 2022; 14(4):2142. https://doi.org/10.3390/su14042142
Chicago/Turabian StyleKalaimurugan, Dharman, Balasubramanian Balamuralikrishnan, Rasiravathanahalli Kaveriyappan Govindarajan, Naif Abdullah Al-Dhabi, Mariadhas Valan Arasu, Chithravel Vadivalagan, Srinivasan Venkatesan, Hesam Kamyab, Shreeshivadasan Chelliapan, and Chartchai Khanongnuch. 2022. "Production and Characterization of a Novel Biosurfactant Molecule from Bacillus safensis YKS2 and Assessment of Its Efficiencies in Wastewater Treatment by a Directed Metagenomic Approach" Sustainability 14, no. 4: 2142. https://doi.org/10.3390/su14042142
APA StyleKalaimurugan, D., Balamuralikrishnan, B., Govindarajan, R. K., Al-Dhabi, N. A., Valan Arasu, M., Vadivalagan, C., Venkatesan, S., Kamyab, H., Chelliapan, S., & Khanongnuch, C. (2022). Production and Characterization of a Novel Biosurfactant Molecule from Bacillus safensis YKS2 and Assessment of Its Efficiencies in Wastewater Treatment by a Directed Metagenomic Approach. Sustainability, 14(4), 2142. https://doi.org/10.3390/su14042142










